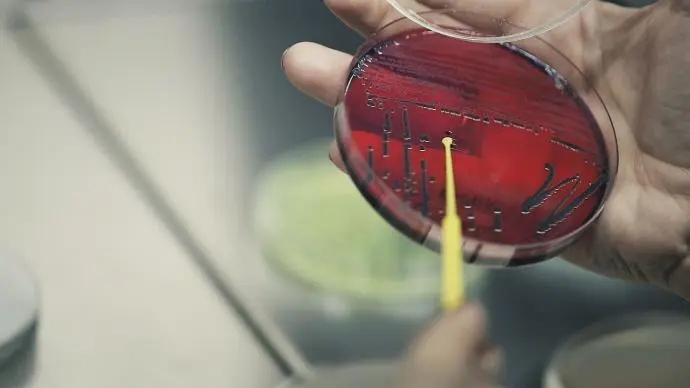

Nos Domaines
Nous proposons des services qui touchent plusieurs domaines: textile habillement, textile technique, cuir & chaussure, cosmétique et agroalimentaire.
Nos Services
Nous offrons des services d'essai, d'étalonnage & de vérification des instruments de mesure, des audits, des formations, des inspections, de l'assistance technique.
Nos Actualités
Nos Références
90%
of accredited tests
95%
Of highly quilified personnel
20 ans
Experience